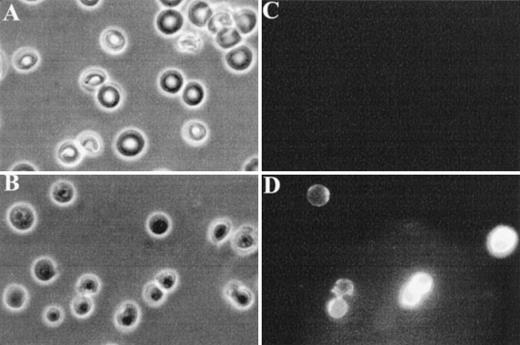
Fig. 4. Fluorescence microscopy analysis of FITC-annexin V binding to RBCs. RBCs were examined after 36 hours of incubation in PBS to facilitate the detection of abnormal cells due to progressive loss of phospholipid asymmetry. Washed RBCs were incubated with FITC-annexin V at room temperature. After two washings in PBS, RBCs were collected by centrifugation at 1,000g and placed between siliconized slide and coverslip. Normal and band 3 null RBCs were examined by phase contrast microscopy (A and B) and fluorescence microscopy (C and D). Note that normal RBCs do not bind FITC-annexin, whereas some band 3 null RBCs show a conspicuous membrane-associated fluorescence reflecting FITCannexin V binding.

Abstract
Only 5% to 10% of band 3 null mice survive the neonatal period. To determine the cause of death, 3 adult and 11 newborn band 3 null mice were submitted for histopathologic examination. All but 1 pup showed evidence of thrombosis including: (1) large thrombotic lesions in the heart, which were partially organized, calcified in some fields, and endothelialized, indicating a process that developed premortem (3 of 3 adults and 6 of 11 pups). (2) Subcapsular necrotic areas in the liver suggestive of premortem ischemic events caused by arteriolar occlusions (8 of 11 pups). (3) Large vein thrombi (4 of 11 pups). To investigate the etiology of this hypercoagulable state, we have used the Russell’s viper venom test (RVV) to show that red blood cells (RBCs) from band 3 null mice significantly shorten the RVV clotting time of normal plasma in a dose-dependent fashion, whereas RBCs from normal mice have no effect, suggesting that the membrane of band 3 null RBCs provides a suitable surface for activation of the prothrombinase complex. Using flow cytometry, we have examined the phosphatidylserine (PS)-specific binding of fluorescein isothiocyanate (FITC)-annexin V to normal and band 3 null RBCs. A subpopulation of cells (3% to 5% of RBCs) with increased FITC-annexin V binding was detected in band 3 null RBCs as compared with normal RBCs. Furthermore, the entire cell population of band 3 null RBCs shows a measurable increase in the mean fluorescence intensity, suggesting that band 3 null RBCs may have increased PS exposure on the outer membrane leaflet. These findings are further supported by direct fluorescence microscopy of normal and band 3 null RBCs labeled with FITC-annexin V. Based on these observations, we postulate that the high mortality of band 3 null mice may be related to a hypercoagulable state, which appears to originate from changes in the phospholipid composition of the membrane leading to PS exposure on the outer leaflet.
© 1998 by The American Society of Hematology.
BAND 3 IS ONE OF the most abundant integral proteins of the red blood cell (RBC) membrane. With ≈ 1.2 × 106 copies per RBC, band 3 constitutes ≈ 25% to 30% of the total protein mass in the purified membrane (for review, see Tanner1 and Low2). The principal role of band 3 is to function as an anion exchange protein (AE1) and to provide mechanical stability to the plasma membrane. The mature protein, consisting of 911 amino acids,3,4 is composed of two structural domains, which can be readily cleaved by trypsin and chymotrypsin, retaining their distinct functions. The 52-kD membrane spanning domain mediates the anion transport function of band 3 thus allowing efflux of HCO3− from the cell in exchange for Cl-.5 The amino terminal 43-kD cytoplasmic domain harbors association sites for several cytoplasmic and membrane-associated proteins. These proteins include (1) several glycolytic enzymes whose activity is modulated by their binding to band 36-8; (2) hemichromes that are produced by oxidation and denaturation of hemoglobin and whose binding to band 3 leads to clustering of band 3 in the membrane9-11; (3) ankyrin whose binding to band 3 is believed to anchor the erythrocyte membrane skeleton to the lipid bilayer12-15; and (4) protein 4.2 and protein 4.1 whose associations with the cytoplasmic domain of band 3 have functional implications for the stability of the membrane.
We and others have recently developed murine animal models in which the expression of erythroid band 3 has been eliminated via targeted mutagenesis.16,17 Although no fetal loss occurs among band 3 null mice, only 5% to 10% of the mice survive the neonatal period. The cause of death is currently unknown. Adult band 3 null mice, which survive the critical neonatal period, display severe hemolytic anemia with characteristic spherocytic RBCs. The band 3 null RBCs have an increased osmotic fragility indicating a low surface area-to-volume ratio due to a marked loss of membrane surface. The loss of membrane is presumed to occur through the shedding of vesicles, an observation substantiated by electron micrographs of band 3 null RBCs, which display vesicles and rod-like membrane structures expanding from the cell surface. These findings are also corroborated by observations made of RBCs from cattle with a naturally occurring homozygous nonsense mutation of the band 3 gene, which exhibit similar properties.18 To investigate the cause of high mortality, we have performed a detailed histopathologic analysis of band 3 null mice. Our results show a striking propensity for thrombosis in newborn and adult band 3 null mice. Mechanistically, the complete loss of band 3 appears to disrupt the phospholipid asymmetry of the red blood cell membrane, thereby generating a membrane surface suitable for the activation of the coagulation cascade.
MATERIALS AND METHODS
Collection and isolation of RBCs.
Whole blood (200 to 300 μL) was collected from control and band 3 null adult mice in heparin-coated glass tubes by retroocular puncture and immediately washed once with phosphate-buffered saline (PBS). After centrifugation, the cells were collected and resuspended in 300 μL of PBS. The cells were then centrifuged at 1,000g for 5 minutes in a pipette tip sealed at the pointed end. After centrifugation, the buffy coat was removed by clipping the open end of the tip, discarding a generous top layer, and RBCs were collected from the bottom by clipping the sealed pointed end. The isolated RBCs were washed twice in PBS. An aliquot of the cells was then used for complete blood count (CBC) and Wright-Giemsa staining. At this stage, the RBC samples are platelet- and white cell-depleted.
Hematologic analysis of adult band 3 null mice.
Previously we reported hematologic measurements on blood collected from 2-day old pups.16 Here we report hematologic measurements on adult band 3 null mice (129/SvJ strain), which suffer from thrombotic lesions. It is worth noting that because of accelerated in vitro clotting, the blood from band 3 null mice has to be collected in the presence of an excess of citrate-phosphate-dextrose buffer anticoagulant (30% vol/vol). The following values were corrected for the dilution factor. RBC count: wild-type (WT), 8.0 ± 0.5 × 106/μL; band 3 null, 2.6 ± 0.4 × 106/μL. Hemoglobin: WT, 11.9 ± 0.4 g/dL; band 3 null, 3.8 ± 0.3 g/dL. Hematocrit: WT, 42.2% ± 1.5%; band 3 null, 15.9% ± 1.6%. Reticulocytes: WT, 2.3% ± 0.3%; band 3 null, 56.0% ± 10%. Platelets: WT, 471 × 103/μL; band 3 null, 539 × 103/μL.
Histopathologic evaluation.
Adult band 3 null mice were killed and major organs including heart, liver, spleen, kidneys, brain, lungs, stomach, colon, small intestine, and esophagus were dissected and fixed in buffered formalin. Newborn pups were killed and fixed in buffered formalin. Sections of organs were examined by light microscopy after staining with hematoxylin and eosin.
Russell’s viper venom (RVV) test.
The RVV test (American Diagnostica Inc, Greenwich, CT) is a one-stage prothrombinase assay in which the conversion of factor X to its active form, factor Xa, is catalyzed by RVV in the presence of calcium and phospholipids. We have adapted this assay, as described previously,19 20 to determine the effect of membrane phospholipids from normal and band 3 null RBCs on the clotting time of normal plasma. Aliquots of citrated platelet-poor plasma (150 μL) were incubated at 37°C with 20 μL of PBS containing predetermined numbers of normal or band 3 null RBCs. After 2 minutes of incubation, 150 μL of RVV test solution containing RVV and calcium were added. The time required for the formation of a fibrin clot was measured with a fibrometer.
Measurement of phosphatidylserine (PS)-mediated binding of fluorescein isothiocyanate (FITC)-annexin V to RBCs by flow-cytometry.
Annexins specifically bind to acidic phospholipids, particularly PS. Flow-cytometric analysis of FITC-annexin V binding to the surface of platelets, platelet-derived microvesicles,21 cells undergoing apoptosis,22 and pathologic RBCs23-25 has been used to quantify PS exposure on the outer membrane leaflet. We have used this assay to detect PS exposure on the surface of normal and band 3 null RBCs using FITC-annexin V (Annexin-V-Fluos; Boehringer Mannheim, Indianapolis, IN). RBCs were collected as described above and immediately processed for labeling with FITC-annexin V. Aliquots of washed RBCs (2 × 106cells) were incubated with FITC-annexin V in 200 μL of a buffer containing 10 mmol/L HEPES/NaOH, pH 7.4, 140 mmol/L NaCl, and 5 mmol/L CaCl2 (buffer A). After incubation for 15 minutes at room temperature, the RBCs were aspirated into a flow cytometer (Coulter EPICS XL model Y44299; Coulter, Fullerton, CA) for analysis (excitation wavelength 488 nm, emission wavelength 545 nm). It is important to point out that membrane vesicles and ghosts were “gated out” using parameters that allow detection of erythrocytes exclusively; the size of membrane vesicles is below the detection level and the forward light scatter of erythrocyte ghosts is beyond the window under examination. This conclusion was reached by studying ghosts and vesicles in independent experiments (data not shown).
Fluorescence microscopy analysis of FITC-annexin V binding to RBCs.
RBCs were collected, washed twice in the labeling buffer A, and incubated with FITC-annexin V as described above. The cells were collected by centrifugation, placed between siliconized slide and coverslip, and examined by fluorescence microscopy.
RESULTS
Band 3 null mice display widespread thrombosis suggesting an underlying hypercoagulable state.
Full-length band 3 (AE1) is believed to be expressed only in RBCs, while a truncated form of the AE1 protein is found in kidneys.1 Our gene targeting construct was engineered to selectively inactivate the transcription of the erythroid band 3 gene.16 To investigate the cause of excessive mortality among band 3 null mice, 11 newborn pups and 3 adult mice that survived the neonatal period were killed and submitted for histopathologic examination of major organs including heart, liver, spleen, kidneys, brain, lungs, stomach, colon, small intestine, and esophagus. Thrombotic lesions around the atrioventricular valves and within the atrial or ventricular chambers were detected in all 3 adult mice and 6 of 11 newborn pups (Fig 1A through C). The thrombotic lesions are large, partially organized, calcified in some fields, and endothelialized, indicating a subacute process that developed premortem. Large vein thrombi were detected in four pups (Fig1D and E). In addition, the liver of 8 band 3 null pups showed subcapsular necrotic areas (Fig 1F), suggesting premortem acute ischemic events caused by small arterial occlusions. All but 1 of the band 3 null mice examined showed evidence of thrombotic lesions. The wide-spread occurrence of thrombotic lesions strongly suggests an underlying hypercoagulable state in band 3 null mice. The considerable size of these thrombi and their critical location in organs such as the heart suggest that thromboembolic events may constitute the major cause of death in band 3 null mice.
Histopathologic analysis of band 3 null mice. Band 3 null pups and organs from band 3 null adult mice were fixed in buffered formalin for histopathologic examination. Tissues were stained with hematoxylin and eosin. (A and B) (original magnification × 20) show characteristic thrombi in the atrial and ventricular cavities. Similar lesions were observed in nine of 12 mice examined. A higher magnification of one thrombus in (C) (original magnification × 60) clearly shows endothelial lining of the organized thrombus, indicating premortem development of the lesion. (D) (original magnification × 40) shows two thrombi in a medium-size vessel in the lung parenchyma. (E) (original magnification × 40) shows a large organized thrombus in the portal vein in one adult band 3 null mouse. (F) (original magnification × 40) shows a liver section from a band 3 null pup revealing subcapsular hepatocellular necrosis suggesting an ischemic event due to a small arterial occlusion. M, myocardium; T, thrombus; RA, right atrium; RV, right ventricle; LA, lung alveoli; H, hepatocytes; N, necrosis.
Histopathologic analysis of band 3 null mice. Band 3 null pups and organs from band 3 null adult mice were fixed in buffered formalin for histopathologic examination. Tissues were stained with hematoxylin and eosin. (A and B) (original magnification × 20) show characteristic thrombi in the atrial and ventricular cavities. Similar lesions were observed in nine of 12 mice examined. A higher magnification of one thrombus in (C) (original magnification × 60) clearly shows endothelial lining of the organized thrombus, indicating premortem development of the lesion. (D) (original magnification × 40) shows two thrombi in a medium-size vessel in the lung parenchyma. (E) (original magnification × 40) shows a large organized thrombus in the portal vein in one adult band 3 null mouse. (F) (original magnification × 40) shows a liver section from a band 3 null pup revealing subcapsular hepatocellular necrosis suggesting an ischemic event due to a small arterial occlusion. M, myocardium; T, thrombus; RA, right atrium; RV, right ventricle; LA, lung alveoli; H, hepatocytes; N, necrosis.
An increased exposure of PS is found on the surface of band 3 null RBCs.
Because band 3 is the most abundant integral protein of the RBC membrane and because it has been ascribed a flippase activity,26-28 we speculated that the hypercoagulable state of band 3 null mice might be related to an altered phospholipid (PL) asymmetry in the membrane of RBCs. In normal human RBCs, the major phospholipids of the membrane are asymmetrically distributed between the two bilayers (for review, see Zwaal and Schroit29 and Williamson and Schlegel30). The cholinephospholipids (sphingomyelin [Sph] and phosphatidylcholine [PC]) are predominantly found in the outer lipid leaflet, whereas the aminophospholipids (phosphatidylserine [PS] and phophatidylethanolamine [PE]) are mainly confined to the inner lipid leaflet. This asymmetric distribution of the phospholipids is the result of a dynamic equilibrium whereby phospholipids are constantly exchanged between the two lipid bilayers by active transport mechanisms. An altered phospholipid asymmetry on the membrane leading to the exposure of PS on the outer leaflet is known to provide a suitable surface for activation of the coagulation cascade and may potentially contribute to the hypercoagulable state of band 3 null mice. We have investigated this possibility using the following complementary approaches.
The RVV test was used to determine the effect of RBCs from normal and band 3 null adult mice on the clotting time of normal plasma. The effect of normal and band 3 null RBCs on the time required for fibrin formation is shown in Fig 2. RBCs from normal adult mice have no effect on the RVV clotting time even at high concentrations, whereas RBCs from adult band 3 null mice significantly shorten the RVV clotting time in a dose-dependent and saturable fashion. In agreement with previously reported results,19 20 these findings suggest that the phospholipid organization in normal erythrocytes does not provide a suitable catalytic surface for activation of the prothrombinase complex. In contrast, the membrane of band 3 null RBCs provides a procoagulant surface that enhances the activation of the prothrombinase complex through the exposure of PS on its outer lipid leaflet.
RVV test. Aliquots (150 μL) of citrated platelet-poor plasma were mixed with 20 μL of PBS containing increasing numbers of normal (•) or band 3 null (○) RBCs from adult mice. After incubation at 37°C for 2 minutes, 150 μL of RVV test solution containing RVV and calcium was added. The time required for the formation of a fibrin clot was measured with a fibrometer. Note that RBCs from normal mice have no effect on the RVV clotting time, whereas RBCs from band 3 null mice significantly shorten the RVV clotting time. The values shown are the mean of four independent experiments ± standard deviation (SD).
RVV test. Aliquots (150 μL) of citrated platelet-poor plasma were mixed with 20 μL of PBS containing increasing numbers of normal (•) or band 3 null (○) RBCs from adult mice. After incubation at 37°C for 2 minutes, 150 μL of RVV test solution containing RVV and calcium was added. The time required for the formation of a fibrin clot was measured with a fibrometer. Note that RBCs from normal mice have no effect on the RVV clotting time, whereas RBCs from band 3 null mice significantly shorten the RVV clotting time. The values shown are the mean of four independent experiments ± standard deviation (SD).
To further demonstrate surface exposure of PS on band 3 null RBCs, we examined the specific binding of FITC-annexin V to RBCs using flow cytometry. Binding of FITC-annexin V to the surface of platelets and platelet-derived microvesicles has been previously used to document PS exposure upon stimulation with various agonists.21 The same approach has also been used to detect PS exposure on the surface of cells undergoing apoptosis22 and has allowed the identification of a subpopulation of RBCs with increased surface exposure of PS in patients with sickle cell anemia.23-25Using flow cytometry, the possibility of abnormal PS exposure on the surface of RBCs from adult band 3 null mice was examined. As shown in Fig 3A, the background fluorescence of normal RBCs incubated with FITC-annexin V is attributed to the nonspecific binding of FITC-annexin V to the surface of the cells. Gate D defines the fluorescence intensity exceeding the level of nonspecific binding and is arbitrarily set to encompass less than 0.5% of normal RBCs. Flow cytometric analysis of band 3 null erythrocytes (Fig 3C) showed a subpopulation of cells (3.8% of the total cell population in the experiment shown; range, 3% to 5% in four independent experiments) exhibiting an increased FITC-annexin V binding as reflected by a fluorescence intensity that is above the defined background level (ie, included within gate D). Importantly, when only the cell population included in gate F (ie, entire cell population excluding cells within gate D) is considered, the band 3 null erythrocytes show a 1.2-fold increase in fluorescence intensity when compared with normal erythrocytes. This experiment, which results are summarized in a tabular form in Fig 3, is representative of four independent experiments that yielded similar findings.
Flow cytometric analysis of FITC-annexin V binding to RBCs. RBCs from normal (+/+) and band 3 null (−/−) mice were examined at the time of collection (0 hour, [A] and [C]) and after 36 hours (B and D) of incubation in PBS. The cells were washed three times in PBS before each measurement. (A) Shows the nonspecific background fluorescence of normal RBCs shortly after collection. Gate D defines the fluorescence intensity exceeding the level of nonspecific binding and is arbitrarily set to encompass less than 0.5% of normal RBCs. (C) Shows a subpopulation of band 3 null RBCs included within gate D (3.8% of the total population in the experiment shown; range, 3% to 5% in four independent experiments with increased FITC-annexin V binding. (B) Shows that normal RBCs show no increase in FITC-annexin V binding when examined 36 hours after collection. The subpopulation of erythrocytes included in gate D remains below 1%. In contrast, the percentage of band 3 null RBCs included in gate D increases to 15.7% at 36 hours (in the experiment shown; range, 15% to 20% in four independent experiments. Importantly, the entire population of band 3 null RBCs shows an increase in FITC-annexin V binding as reflected by the doubling of the mean fluorescence of the cell population included within gate F (entire cell population excluding cells in gate D), whereas no significant change is detected in normal cells. This experiment, which results are summarized in a tabular form, is representative of four independent experiments that yielded similar findings.
Flow cytometric analysis of FITC-annexin V binding to RBCs. RBCs from normal (+/+) and band 3 null (−/−) mice were examined at the time of collection (0 hour, [A] and [C]) and after 36 hours (B and D) of incubation in PBS. The cells were washed three times in PBS before each measurement. (A) Shows the nonspecific background fluorescence of normal RBCs shortly after collection. Gate D defines the fluorescence intensity exceeding the level of nonspecific binding and is arbitrarily set to encompass less than 0.5% of normal RBCs. (C) Shows a subpopulation of band 3 null RBCs included within gate D (3.8% of the total population in the experiment shown; range, 3% to 5% in four independent experiments with increased FITC-annexin V binding. (B) Shows that normal RBCs show no increase in FITC-annexin V binding when examined 36 hours after collection. The subpopulation of erythrocytes included in gate D remains below 1%. In contrast, the percentage of band 3 null RBCs included in gate D increases to 15.7% at 36 hours (in the experiment shown; range, 15% to 20% in four independent experiments. Importantly, the entire population of band 3 null RBCs shows an increase in FITC-annexin V binding as reflected by the doubling of the mean fluorescence of the cell population included within gate F (entire cell population excluding cells in gate D), whereas no significant change is detected in normal cells. This experiment, which results are summarized in a tabular form, is representative of four independent experiments that yielded similar findings.
There remains the possibility that some RBC ghosts and vesicles may be present among the RBCs and conceivably contribute to the procoagulant activity of the RBC population detected by the RVV test. However, it is important to mention that in the flow cytometry studies, vesicles and ghosts have been “gated out” using parameters that focus exclusively on erythrocytes. The size of membrane vesicles is below the level of detection, and the forward light scatter of erythrocyte ghosts is above the window under examination. We have confirmed this fact by studying purified ghosts and vesicles in independent experiments (data not shown).
It is pertinent to mention here that RBCs isolated from band 3 null mice contain a higher percentage of reticulocytes than their normal counterparts (56.0% ± 10% v 2.3% ± 0.3%). We have examined the effect of elevated reticulocytosis on the RVV clotting time, as well as on annexin binding as assessed by flow cytometry. The results are as follows: (1) RBCs isolated from normal pups contain 30% to 40% reticulocytes and yet show no propensity to shorten the RVV clotting time and no increase in the annexin V binding as measured by flow cytometry. Therefore, the properties of neonatal RBCs, as assessed by these two methods, are identical to those of adult normal mice that contain only 2% to 3% of reticulocytes. (2) Normal mice were treated with subcutaneous injections of phenylhydrazine for 5 days to boost the percentage of reticulocytes to 50%. Again, RBCs from phenylhydrazine-treated mice had no effect on the RVV clotting time. These data strongly suggest that an increased reticulocytosis cannot account for the abnormal findings observed in the band 3 null RBC population.
These data, together with the results of the RVV test, suggest that band 3 null RBCs, when examined shortly after collection, contain a subpopulation of cells with increased PS exposure on the outer membrane leaflet. Furthermore, the entire cell population exhibits an increased affinity for FITC-annexin V binding, thus reflecting that band 3 null erythrocytes as a whole exhibit more PS on their outer lipid leaflet. Based on these results, we postulate that the altered phospholipid asymmetry in the plasma membrane may be responsible for the procoagulant activity of band 3 null RBCs in vivo.
Finally, fluorescence microscopy was used to visualize FITC-annexin V binding to normal and band 3 null RBCs. As shown in Fig 4C, normal RBCs do not show detectable binding of FITC-annexin V, whereas a subpopulation of band 3 null RBCs shows a conspicuous membrane-associated fluorescence indicating an abnormal exposure of PS on the cell surface (Fig 4D).
Fluorescence microscopy analysis of FITC-annexin V binding to RBCs. RBCs were examined after 36 hours of incubation in PBS to facilitate the detection of abnormal cells due to progressive loss of phospholipid asymmetry. Washed RBCs were incubated with FITC-annexin V at room temperature. After two washings in PBS, RBCs were collected by centrifugation at 1,000g and placed between siliconized slide and coverslip. Normal and band 3 null RBCs were examined by phase contrast microscopy (A and B) and fluorescence microscopy (C and D). Note that normal RBCs do not bind FITC-annexin, whereas some band 3 null RBCs show a conspicuous membrane-associated fluorescence reflecting FITCannexin V binding.
Fluorescence microscopy analysis of FITC-annexin V binding to RBCs. RBCs were examined after 36 hours of incubation in PBS to facilitate the detection of abnormal cells due to progressive loss of phospholipid asymmetry. Washed RBCs were incubated with FITC-annexin V at room temperature. After two washings in PBS, RBCs were collected by centrifugation at 1,000g and placed between siliconized slide and coverslip. Normal and band 3 null RBCs were examined by phase contrast microscopy (A and B) and fluorescence microscopy (C and D). Note that normal RBCs do not bind FITC-annexin, whereas some band 3 null RBCs show a conspicuous membrane-associated fluorescence reflecting FITCannexin V binding.
Band 3 null red blood cells undergo a progressive loss of phospholipid asymmetry.
The exposure of PS on the outer lipid leaflet serves as a recognition signal for capture and clearance of cells by macrophages. Therefore, RBCs that have lost the normal phospholipid asymmetry are likely to be rapidly cleared from circulation in vivo. We hypothesized that as cells circulate in vivo, the randomization of phospholipids may slowly progress over time, thus triggering macrophage recognition and clearance. Because the macrophage clearance mechanism is absent in vitro, we anticipated that band 3 null RBCs may show a progressive loss of phospholipid asymmetry when compared with normal cells. We tested this hypothesis by analyzing in vitro the binding of FITC-annexin V to normal and band 3 null erythrocytes after incubation of the cells on ice, for 36 hours, in PBS. As shown in Fig 3A and B, normal RBCs show a steady level of fluorescence when examined over a period of 36 hours. The subpopulation of erythrocytes showing a level of fluorescence intensity exceeding the level of nonspecific binding (included in gate D) remains below 1% over the course of 36 hours of incubation on ice. In contrast, the percentage of band 3 null RBCs showing a fluorescence intensity above background increases steadily from 3.8% shortly after collection (0 hour) to 15.7% at 36 hours (in the experiment shown; range, 15% to 20% in four independent experiments) (Fig 3C and D). Importantly, the entire population of band 3 null cells included within gate F shows a nearly twofold increase in the mean fluorescence level, whereas no significant increase is observed in normal cells. This experiment, which results are summarized in a tabular form in Fig 3, is representative of four independent experiments that yielded similar findings. In addition, we have examined the adenosine triphosphate (ATP) content of band 3 null RBCs and have excluded the possibility that the loss of phospholipid asymmetry in these cells is simply due to depletion of intracellular ATP (data not shown). This conclusion is further buttressed by the observation of a similar increase in annexin binding to band 3 null RBCs occuring even when the cells are incubated in CPDA (citrate/phosphate/dextrose/adenine). In summary, these observations support our hypothesis that RBCs from band 3 null mice undergo a progressive loss of membrane phospholipid asymmetry in vitro.
DISCUSSION
Membrane anionic phospholipids play a crucial role at several levels of the coagulation pathway. These phospholipids provide an essential attachment surface for coagulation factors, thereby promoting their assembly into potent enzymatic complexes and enhancing their catalytic activity. These coagulation factors include the tissue factor/factor VII complex of the extrinsic pathway,31,32 as well as the tenase and prothrombinase complexes of the intrinsic pathway.33 PS has been shown to be the most effective phospholipid in supporting this procoagulant function, and the presence of a negatively charged PS on the cell surface produces a million fold increase in the rate of thrombin formation. Although the proteins responsible for the phospholipid translocation across the membrane have not yet been identified, several studies have shown that the phospholipid asymmetry in the membrane is regulated by three major protein activities: (1) The ATP-dependent aminophospholipid translocase activity is characterized by its ability to transport PS and PE from the outer to the inner leaflet (flip)34-36; (2) an ATP-dependent floppase activity allows the transport of both aminophospholipids and cholinephospholipids from the inner to the outer leaflets (flop)35,37,38; and (3) a scramblase activity is known to disrupt the lipid asymmetry within minutes in the presence of increased cytoplasmic calcium.39 40
The results reported here suggest that the phospholipid asymmetry is altered in the membrane of band 3 null RBCs. These abnormal erythrocytes show an excessive exposure of PS on the surface as assessed by prothrombinase and FITC-annexin V binding assays. We postulate that the altered phospholipid distribution may play a role in the development of a hypercoagulable state in the band 3 null mice. Indeed, loss of phospholipid asymmetry has previously been implicated in the thrombogenic potential of pathologic RBCs. Sickle erythrocytes are known to accelerate clotting in vitro,19 and the deoxygenation of RBCs from sickle cell patients results in a reduced transbilayer movement of PS41 leading to loss of phospholipid asymmetry. Furthermore, a subpopulation (2% to 3%) of sickle cell RBCs exhibits a substantial increase in PS exposure when assessed by flow cytometry analysis of fluorescent annexin V binding.24,25 It has been suggested that even a small number of abnormal sickle cells with altered phospholipid asymmetry could induce a substantial thrombogenic effect and may contribute to the hypercoagulable state observed in sickle cell anemia.25Similarly, the loss of phospholipid asymmetry has been implicated in the increased incidence of thrombotic events observed in patients with thalassemia.42,43 RBCs from thalassemic patients examined by the prothrombinase assay display a procoagulant activity indicating an excessive exposure of PS on the outer leaflet.42
In addition to its modulating effect on the coagulation pathway, the loss of phospholipid asymmetry in the membrane has two other major consequences: (1) it results in recognition and clearance of altered RBCs by macrophages.44 This phagocytosis can be completely inhibited by artificial PS vesicles, suggesting that the presence of PS on the surface of RBCs may represent the sole recognition signal for attachment and clearance of these cells by macrophages.45Incorporation of PS in the outer leaflet exceeding 1 to 2 mol% was determined to be the threshold level beyond which abnormal RBCs are recognized and cleared from circulation in vivo.46,47 A similar mechanism for the clearance of apoptotic cells has also been demonstrated.22,48 (2) The loss of phospholipid asymmetry has been correlated with vesiculation of the plasma membrane. The influx of calcium in platelets and RBCs induces shedding of vesicles from the plasma membrane.21,49-51 This event is synchronous with the development of a procoagulant surface due to the loss of phospholipid asymmetry in the membrane of remnant platelets.49 Loss of phospholipid asymmetry and vesiculation are also recognized synchronous events of cells undergoing apoptosis. Furthermore, the translocation of PS to the outer leaflet precedes and facilitates membrane fusion.49,50 Because blebbing and shedding of microvesicles entails fusion of apposing segments of plasma membrane, it has been proposed that membrane fusion and vesiculation are two consequences of the loss of phospholipid asymmetry in the membrane.52-54
Here, we propose a model that provides an explanation for the hypercoagulable state and the RBC phenotype of band 3 null mice. The complete loss of band 3 produces changes in the phospholipid composition of the membrane leading to an accelerated loss of phospholipid asymmetry in circulating RBCs. The consequent exposure of PS on the cell surface results in the activation of the prothrombinase complex by providing a procoagulant anionic phospholipid surface, thereby generating a hypercoagulable state. The loss of membrane asymmetry could also contribute to the shedding of membrane vesicles thereby leading to the spherocytic shape of band 3 null erythrocytes. Because these membrane vesicles are also likely to retain the altered phospholipid distribution, membrane vesiculation may accentuate the procoagulant activity in vivo. Finally, the PS exposure on the surface of band 3 null erythrocytes is likely to trigger their clearance by macrophages, accounting for the shortened life span of these cells in vivo.
The proposed model, which ascribes to band 3 a role in the maintenance of the membrane phospholipid asymmetry, is consistent with the recently reported flippase function of band 3.26-28 The evidence for the flippase activity of band 3 is based on several observations. The translocation of anionic amphiphiles (1-palmitoyl-sn-glycero-3-phosphomethanol and 5-aminonaphtalene-2-sulfonic acid) is hindered by several established inhibitors of band 3-mediated anion exchange including stilbene disulfonates (H2 DIDS or DIDS).26 The translocation of these lipids was accelerated after external proteolysis of band 3 with papain, which cleaves band 3 and affects its anion transport function.26 A similar role of band 3 has also been described for the flip of a long chain amphiphilic anion, 5-(N-decyl)aminonaphtalene-2-sulfonate (DENSA).27Likewise, the translocation of several mono- and divalent anionic fluorescent phospholipids was modulated by selected inhibitors of the anion exchange function of band 3 and by treatment with papain.28 However, it is worth noting that the proposed model may be more complex in view of the recently published data reporting thrombosis as a major complication in two murine models of hereditary spherocytosis in which the primary genetic defects involved α and β spectrin.55
This model is also consistent with several studies that suggest an interaction between membrane proteins and surrounding phospholipids. Nuclear magnetic resonance measurements have provided evidence for at least two phospholipid domains in the presence of membrane proteins; one resembles normal phospholipid bilayer, whereas the other domain appears to be motionally restricted. These studies are consistent with phospholipids tightly bound to the membrane proteins and undergoing rotational diffusion. It is intriguing to note that glycophorin A, which is missing in the membrane of band 3 null RBCs,56preferentially associates with the anionic phospholipids PS and PI.57-60
In summary, we have provided evidence that band 3 null mice have a hypercoagulable state, which is likely to be responsible for the high neonatal mortality. The data presented are consistent with the notion that band 3, either directly or in association with other proteins, modulates the phospholipid distribution in the membrane of erythrocytes. However, there remains the possibility that altered phospholipid asymmetry in the membrane of other cells (ie, platelets and endothelial cells), where small amounts of the AE1 transcript have been detected, may also contribute to the overall hypercoagulable state of band 3 null mice.
ACKNOWLEDGMENT
The authors thank Donna-Marie Mironchuk for the artwork.
Supported by Grants No.HL 51445 and CA 66263 (to A.H.C.) and KO8 HL02720 (to H.H.) from the National Institutes of Health. A.H.C. is an established investigator of the American Heart Association.
Address reprint requests to Athar H. Chishti, PhD, ACH4, St Elizabeth’s Medical Center, 736 Cambridge St, Boston, MA 02135.
The publication costs of this article were defrayed in part by page charge payment. This article must therefore be hereby marked "advertisement" is accordance with 18 U.S.C. section 1734 solely to indicate this fact.


![Fig. 3. Flow cytometric analysis of FITC-annexin V binding to RBCs. RBCs from normal (+/+) and band 3 null (−/−) mice were examined at the time of collection (0 hour, [A] and [C]) and after 36 hours (B and D) of incubation in PBS. The cells were washed three times in PBS before each measurement. (A) Shows the nonspecific background fluorescence of normal RBCs shortly after collection. Gate D defines the fluorescence intensity exceeding the level of nonspecific binding and is arbitrarily set to encompass less than 0.5% of normal RBCs. (C) Shows a subpopulation of band 3 null RBCs included within gate D (3.8% of the total population in the experiment shown; range, 3% to 5% in four independent experiments with increased FITC-annexin V binding. (B) Shows that normal RBCs show no increase in FITC-annexin V binding when examined 36 hours after collection. The subpopulation of erythrocytes included in gate D remains below 1%. In contrast, the percentage of band 3 null RBCs included in gate D increases to 15.7% at 36 hours (in the experiment shown; range, 15% to 20% in four independent experiments. Importantly, the entire population of band 3 null RBCs shows an increase in FITC-annexin V binding as reflected by the doubling of the mean fluorescence of the cell population included within gate F (entire cell population excluding cells in gate D), whereas no significant change is detected in normal cells. This experiment, which results are summarized in a tabular form, is representative of four independent experiments that yielded similar findings.](https://ash.silverchair-cdn.com/ash/content_public/journal/blood/92/5/10.1182_blood.v92.5.1785/4/m_blod41717003x.jpeg?Expires=1765015830&Signature=QD9ARQicYnKJywMdyWMSnsppQvAY5BTNelsGhajUdGsDsJYS7-KLw8b0rFwPCtKlFmcuL7tgMCWYlNQK9DtiBIJk8oPZtCj-lcbrh5nlURspCrXAu0KVDQSw40hic~Q4~6uZe7CfFeiThpP9aWjLdHR-Gpm3Jfb3PXPe36Sm3yShIto8ql61aSbU7YlZHx8CnzXzIudl-ugGyQYJX4rmq6BezGZrTohA65Djk1CDTzcbZyrnGwvOO8aF6V0me8QcRhMwcSgKVDh2gLNYEqxMy7sMSIf-zi~g8KgGUs91PcQ7wYI9d0paQacBH0LlUFebexRjCtjrPGI3nOpweriyAQ__&Key-Pair-Id=APKAIE5G5CRDK6RD3PGA)
This feature is available to Subscribers Only
Sign In or Create an Account Close Modal